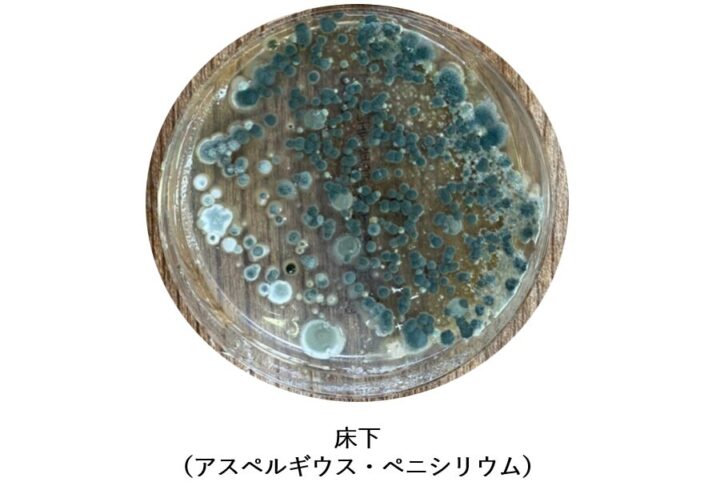
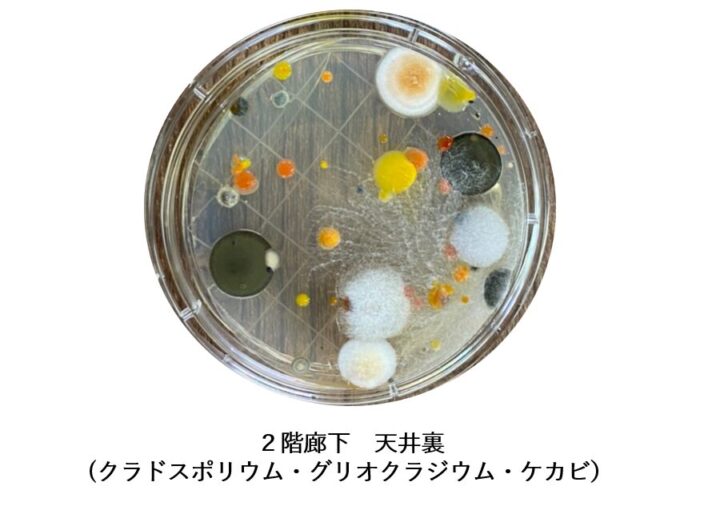

宿舎にて、居室や共用部を中心にカビが発生しているとのご相談を受け、ハーツリッチ株式会社(ハーツクリーン)が現地調査を実施しました。
宿舎のような生活空間では、湿気や通気不足、家具裏のホコリなどが重なることで、カビが目に見えない範囲まで広がっていることがあります。
今回は、目視確認に加え、菌数測定や培養調査を行い、発生状況と原因の傾向を確認しました。
以下では、その調査内容と結果を、実際の事例としてご紹介します。
1. 現地で確認されたカビの状況

今回の調査では、現地での目視確認を行い、建物内のカビ発生状況を把握しました。
1-1. 居室の壁面や家具まわりに見られたカビ
複数の居室では、壁面に加え、家具の裏側やベッドまわりでもカビの発生が確認されました。
見える場所だけでなく、日常清掃が届きにくい場所でも汚染が進んでいたことが特徴です。
1-2. 廊下やエントランスにも広がっていた汚染
カビは個室内だけでなく、廊下やエントランスなどの共用部にも確認されました。
人の出入りや空気の流れによって、胞子が建物内に広がっていた可能性があります。
1-3. ラウンジ・キッチンまわりでも高い菌数を確認
生活動線上にあたるラウンジやキッチンまわりでも、カビの発生が確認されました。
一部の部屋だけの問題ではなく、生活空間全体にカビの影響が及んでいる状況でした。
1-4. 一部の天井裏では黒カビも確認

室内全体では青カビ系の発生が中心でしたが、一部の天井裏では黒カビも確認されました。
こちらは室内全体の汚染とはやや性質が異なり、配管まわりの結露など局所的な要因が関係している可能性があります。
2. 見た目では分からない汚染を数値化する「菌数測定」
カビは見た目だけでは汚染の程度を正確に把握できないため、今回は表面の菌数測定を行いました。
2-1. 検査の目的と判定基準
今回の測定では、各所を拭き取り採取し、表面に付着している菌の量を確認しました。
菌数は、以下の基準に沿って評価しています。
| 菌数(CFU/100cm²) | 判定 |
|---|---|
| 0〜500 | 清潔 |
| 501〜3,000 | 注意 |
| 3,001以上 | 汚染 |
2-2. 主な測定結果
各調査箇所における主な菌数測定結果は、以下のとおりです。
| 測定場所 | 菌数 | 判定 |
|---|---|---|
| 1階 廊下 壁面 | 8,022 | 汚染 |
| 1階 居室A 壁面 | 717 | 注意 |
| 1階 居室A 家具裏 | 17,526 | 汚染 |
| 1階 居室B 壁面 | 25,111 | 汚染 |
| 1階 居室B ベッド裏 | 112,854 | 汚染 |
| 2階 廊下 壁面 | 4,600 | 汚染 |
| 2階 居室 壁面 | 572 | 注意 |
| 2階 居室 家具裏 | 1,198 | 注意 |
| エントランス 壁面 | 874 | 注意 |
| エントランス 額縁 | 測定上限超過 | 汚染 |
| ラウンジ・キッチン | 36,826 | 汚染 |
2-3. 見えにくい場所ほど高菌数だった点が特徴

今回の調査では、壁面よりも、家具裏やベッド裏などの見えにくい場所で特に高い菌数が確認されました。
このことから、見えているカビだけを拭き取っても、根本的な解決にはつながりにくい状況だったと考えられます。
また、額縁やキッチンまわりなど、生活空間の中でも意識しにくい箇所で高い数値が出ており、胞子が空間全体に広がっていた可能性が示唆されました。
3. 培養調査で確認された菌の種類

菌数だけでなく、どのようなカビが発生しているのかを確認するため、培養調査も実施しました。
3-1. 検出された主な菌の種類
培養調査では、主に以下のような菌が確認されました。
| 主な確認菌 | 特徴 |
|---|---|
| アスペルギルス | 室内で広く見られる代表的なカビ |
| ペニシリウム | いわゆる青カビ系として知られるカビ |
| クラドスポリウム | 黒カビとして扱われることが多いカビ |
| 酵母 | 湿気のある環境で見られることがある |
| ケカビ類 | 湿潤環境で発生しやすい菌群 |
3-2. 調査結果から分かった傾向
調査の結果、全体としては青カビ系の発生が多い傾向が確認されました。
青カビは胞子が飛散しやすく、家具裏や生活空間の各所に広がりやすい特徴があります。
一方で、一部の天井裏では黒カビも確認されており、発生箇所によってカビの種類に違いが見られました。
4. カビ発生の主な原因についての考察

ここでは、現地確認・菌数測定・培養調査の結果を踏まえて、発生原因の傾向を整理します。
4-1. 湿度が高くなりやすい環境条件
報告書では、周辺環境や建物条件の影響から、もともと胞子量が多く、湿度が高くなりやすい環境であった点が示されています。
こうした条件が、青カビ系のカビが発生しやすい環境につながったと考えられます。
4-2. 家具裏やベッド裏が発生箇所になった可能性
家具の裏やベッド裏は、空気が滞留しやすく、ホコリがたまりやすい場所です。
今回の調査でもこうした箇所で高い菌数が確認されており、発生源のひとつになった可能性があります。
4-3. 空調の風や人の動きによる拡散
宿舎は日常的に人が生活する空間であるため、歩行やドアの開閉、空調の風などによって胞子が巻き上がりやすい環境です。
一度発生した青カビが、生活動線に沿って空間全体へ広がっていったことが考えられます。
4-4. 天井裏の黒カビは配管結露の可能性
一部の天井裏の黒カビについては、冷媒管まわりの結露水が影響した可能性が高いと考えられます。
そのため、室内全体の青カビ汚染と天井裏の黒カビは、同じ原因ではなく、別の要因で発生していた可能性があります。
5. 調査結果を踏まえた対応内容

今回の調査結果から、表面清掃だけで解決できる状態ではないと判断されました。
そのため、対応は部分的ではなく、空間全体を前提に考える必要があります。
5-1. 部屋全体と家具を含めた除カビ・防カビ
全体に菌数が高かったため、居室だけでなく家具を含めた除カビ・防カビ対応が重要です。
見えているカビだけを除去しても、見えない場所に胞子が残っていれば再発につながります。
5-2. 湿度管理の見直し
再発防止のうえで特に重要なのが湿度管理です。
空調停止時に室内の温湿度が上がりやすい環境では、常時運転できる除湿機や空調管理の見直しが必要になります。
5-3. こまめな掃除と換気
ホコリはカビの栄養源になりやすいため、日常的な清掃も欠かせません。
また、空気の滞留を防ぐため、天候や湿度条件を見ながら適切に換気することも重要です。
5-4. 天井裏など局所的な結露対策
天井裏で確認された黒カビについては、カビ除去だけでなく、必要に応じてボード交換や配管断熱などの設備対応も検討すべき状況です。
局所的な湿潤原因を取り除くことで、再発リスクを下げることができます。
6. まとめ
今回の調査では、建物内全体に青カビ系の汚染が広がっており、特に家具裏やベッド裏、ラウンジ、キッチンまわりなどで高い菌数が確認されました。
また、一部の天井裏では、配管結露の影響が疑われる黒カビも確認されています。
このようなケースでは、見えているカビだけを除去するのではなく、発生原因を把握したうえで除カビ・防カビを行い、さらに湿度管理、換気、清掃まで含めて対応することが重要です。
ハーツリッチ株式会社(ハーツクリーン)では、建物の状態や利用環境に応じた調査・分析を行っています。
施設内のカビやカビ臭、再発を繰り返す汚染でお困りの際は、お気軽にご相談ください。

